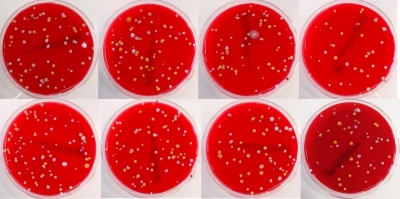
Esta es una pequeña parte de las bacterias que salpican nuestro baño

Ciencia y Tecnología
Evitar que las bacterias y los gérmenes se propaguen depende de pequeñas rutinas. Una de ellas es la expuesta por el científico, José Ramón Vivas, quien está dedicando toda su carrera a entender y difundir los misterios de estas minúsculas partículas que tantos problemas pueden llegar a causarnos.
El magnate Jeff Bezos, fundador de Amazon, costea la construcción de un ingenio que mide el tiempo en años, siglos y milenios para reflejar "el pensamiento a largo plazo"
De los 2.000 millones de teléfonos vendidos por Apple desde que lanzó el modelo, 750 millones están estropeados o no se utilizan.
Más...
El científico británico Stephen Hawking respondió en el programa StarTalk a una incógnita que ha obsesionado a los científicos desde hace siglos.
Un equipo de 'youtubers' captó la increíble habilidad del artista marcial chino a velocidad extremadamente ralentizada.
Una usuaria italiana desafió a la red social con una estatuilla fechada a fines de la última glaciación y, según opinan los administradores, recibió su merecido: no debería haberla publicado.
La investigación sobre las causas y el tratamiento de la disfunción sexual femenina es escasa, pero ahora algunos médicos usan la terapia con láser para ayudar a las mujeres a disfrutar nuevamente del sexo.